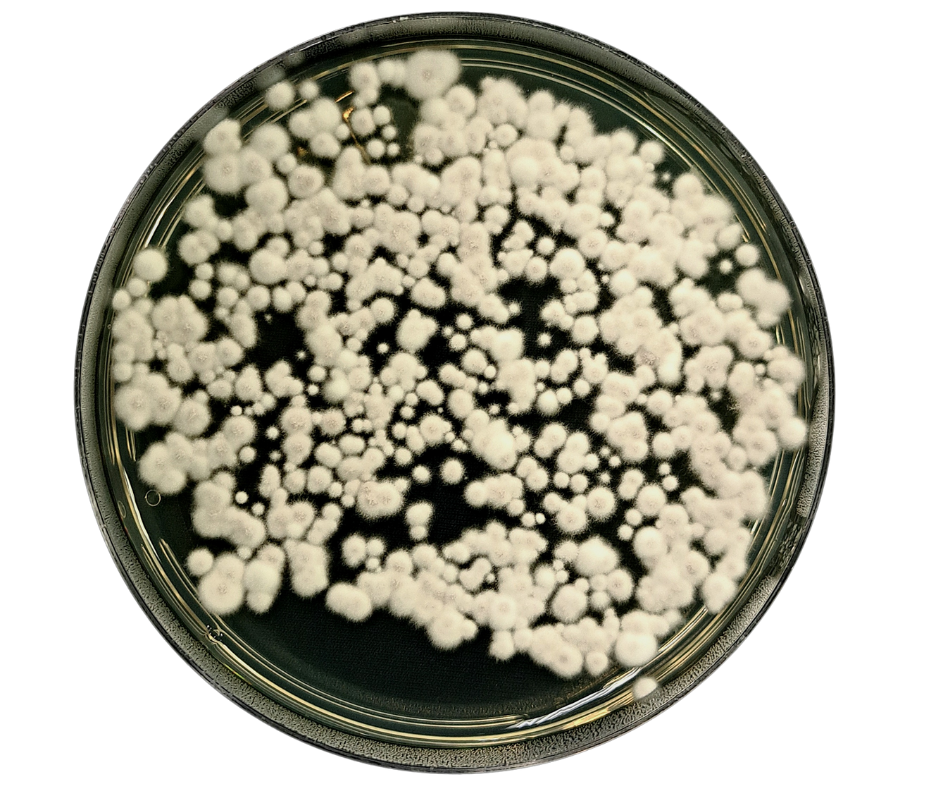

Aptur – PF ®
Inseticida biológico de alta performance, com amplo espectro de ação em insetos-praga de grande importância agrícola.
Características
- Inseticida microbiológico à base do fungo entomopatogênico Isaria fumosorosea;
- Concentração mínima: 1 x 10⁴ UFC/mL;
- Tecnologia Bioshock;
- Formulação: Concentrado solúvel (SL).

Alvo


Cigarrinha-do-milho (Dalbulus maidis)


Bicudo da cana-de-açucar (Sphenophorus levis)


Mosca branca (Bemisia tabaci)
Benefícios
Downloads
Para acessar os documentos necessários, clique nos arquivos disponíveis ao lado e inicie o download. Certifique-se de salvar os documentos em um local de fácil acesso para consultá-los sempre que precisar.
2026 - Agrobiológica - Todos os direitos reservados
Site feito com 🧡 por